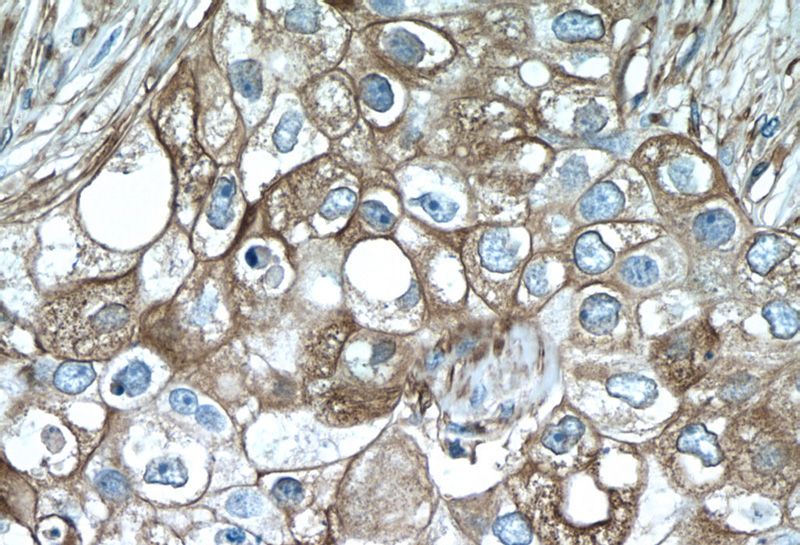
Immunohistochemistry of paraffin-embedded human breast cancer tissue slide using Catalog No:116288(TNF-a Antibody) at dilution of 1:50 (under 40x lens)

-
Product Name
TNF-alpha antibody
- Documents
-
Description
TNF-alpha Rabbit Polyclonal antibody. Positive IHC detected in human breast cancer tissue, human liver cancer tissue, human tonsillitis tissue.
-
Tested applications
ELISA, IHC
-
Species reactivity
Human; other species not tested.
-
Alternative names
Cachectin antibody; DIF antibody; TNF antibody; TNF a antibody; TNF alpha antibody; TNFA antibody; TNFSF2 antibody; Tumor necrosis factor antibody
-
Isotype
Rabbit IgG
-
Preparation
This antibody was obtained by immunization of TNF-alpha recombinant protein (Accession Number: NM_000594). Purification method: Antigen affinity purified.
-
Clonality
Polyclonal
-
Formulation
PBS with 0.02% sodium azide and 50% glycerol pH 7.3.
-
Storage instructions
Store at -20℃. DO NOT ALIQUOT
-
Applications
Recommended Dilution:
IHC: 1:20-1:200
-
Validations

Immunohistochemistry of paraffin-embedded human breast cancer tissue slide using Catalog No:116288(TNF-a Antibody) at dilution of 1:50 (under 10x lens)
Immunohistochemistry of paraffin-embedded human breast cancer tissue slide using Catalog No:116288(TNF-a Antibody) at dilution of 1:50 (under 40x lens)
-
Background
TNF, as also known as TNF-alpha, or cachectin, is a multifunctional proinflammatory cytokine that belongs to the tumor necrosis factor (TNF) superfamily. It is expressed as a 26 kDa membrane bound protein and is then cleaved by TNF-alpha converting enzyme (TACE) to release the soluble 17 kDa monomer, which forms homotrimers in circulation. It is produced chiefly by activated macrophages, although it can be produced by many other cell types such as CD4+ lymphocytes, NK cells, neutrophils, mast cells, eosinophils, and neurons. It can bind to, and thus functions through its receptors TNFRSF1A/TNFR1 and TNFRSF1B/TNFBR. This cytokine is involved in the regulation of a wide spectrum of biological processes including cell proliferation, differentiation, apoptosis, lipid metabolism, and coagulation. This cytokine has been implicated in a variety of diseases, including autoimmune diseases, insulin resistance, and cancer.
-
References
- Dong X, Luo M, Huang G. Relationship between irradiation-induced neuro-inflammatory environments and impaired cognitive function in the developing brain of mice. International journal of radiation biology. 91(3):224-39. 2015.
- Gu Y, He Y, Zhang X. Deficiency of monoclonal non-specific suppressor factor beta (MNSFB) promotes pregnancy loss in mice. Molecular reproduction and development. 82(6):475-88. 2015.
- Yang T, Shi R, Chang L. Huachansu suppresses human bladder cancer cell growth through the Fas/Fasl and TNF- alpha/TNFR1 pathway in vitro and in vivo. Journal of experimental & clinical cancer research : CR. 34:21. 2015.
- Dong D, Yin L, Qi Y, Xu L, Peng J. Protective Effect of the Total Saponins from Rosa laevigata Michx Fruit against Carbon Tetrachloride-Induced Liver Fibrosis in Rats. Nutrients. 7(6):4829-50. 2015.
- Ren JG, Man QW, Zhang W. Elevated Level of Circulating Platelet-derived Microparticles in Oral Cancer. Journal of dental research. 95(1):87-93. 2016.
- Wen J, Zeng M, Shu Y. Aging increases the susceptibility of cisplatin-induced nephrotoxicity. Age (Dordrecht, Netherlands). 37(6):112. 2015.
- Nie D, Zhang D, Dai J. Nicotine Induced Murine Spermatozoa Apoptosis via Up-Regulation of Deubiquitinated RIP1 by Trim27 Promoter Hypomethylation. Biology of reproduction. 94(2):31. 2016.
- Gong Y, Li H, Li Y. Effects of Bacillus subtilis on Epithelial Tight Junctions of Mice with Inflammatory Bowel Disease. Journal of interferon & cytokine research : the official journal of the International Society for Interferon and Cytokine Research. 36(2):75-85. 2016.
Related Products / Services
Please note: All products are "FOR RESEARCH USE ONLY AND ARE NOT INTENDED FOR DIAGNOSTIC OR THERAPEUTIC USE"
